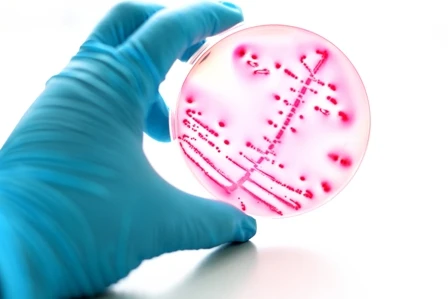

Während der Dow Jones vor Kurzem ein neues Rekordhoch erklommen hat, präsentiert sich der DAX saft- und kraftlos. Doch gute Chancen gibt es an der Börse immer. DER AKTIONÄR sagt Ihnen, welche.
Die AKTIONÄR-Redaktion ist sich sicher: Deutsche Aktien können mehr als derzeit. Viel mehr. Es tut sich nämlich einiges in der hiesigen Wirtschaft: Fusionsgerüchte um Commerzbank und Deutsche Bank, Aufspaltung von ThyssenKrupp, neuer Chef bei Daimler sind nur einige Beispiele für jede Menge Action.
Für die aktuelle Titelstory hat DER AKTIONÄR die 25 Aktien analysiert, die die Deutschen am meisten interessieren. Auf der Liste finden sich Dauerbrenner wie Apple, Commerzbank und Amazon, aber auch Senkrechtstartet wie NEL und Aurora Cannabis sowie Comeback-Werte wie QSC.
Kaufen, halten, verkaufen – in der neuen Ausgabe des AKTIONÄR erfahren Sie, wie Sie sich bei Ihren persönlichen Top-Aktien am besten positionieren.
Alle Infos gibt es in der aktuellen Ausgabe 41/2018 vom AKTIONÄR, die Sie hier bequem als ePaper herunterladen können.
Weitere Themen im Heft:
Der Keim-Killer
Der Börsenneuling sagt Krankenhauskeimen den Kampf an. Mit einem neuartigen Antibiotika soll der Durchbruch gelingen. DER AKTIONÄR erklärt, warum dieses Unternehmen jetzt in das spekulative Depot gehört.

Kleine Alleskönner, große Chance
Antikörper spielen in der Medikamenten-Entwicklung eine wichtige Rolle. Unser „Top-Tipp Spekulativ“ ist hier sehr gut positioniert. Die Pipeline ist mit hoch interessanten Antikörper-Projekten prall gefüllt. Noch 2018 werden hierzu gleich mehrere wichtige Studienergebnisse erwartet.

Leckere Filetstücke
Es war eine lange Hängepartie. Doch jetzt haben Anleger endlich Gewissheit. ThyssenKrupp hat eine neue Führungsriege, zudem wird das Industriekonglomerat in zwei Teile zerlegt. Es ist die letzte Chance für einen Befreiungsschlag.

Hey Doc, ich brauch mehr Dope
Amerika beginnt den Kampf gegen die Opioide-Sucht. Ein möglicher Profiteur ist GW Pharmaceuticals. Die Aktie ist ein Kauf.

Die aktuelle Ausgabe 41/18 des AKTIONÄR erhalten Sie hier.

Hier geht's zum Abo!
E-Mail: abo@boersenmedien.de
SMS oder Whatsapp: +49 151-40508233
Telefon: +49 9221-9051-110

 DER AKTIONÄR – Unsere App
DER AKTIONÄR – Unsere App

05.10.2018, 10:00
05.10.2018, 10:00


 Sofortkauf
Sofortkauf